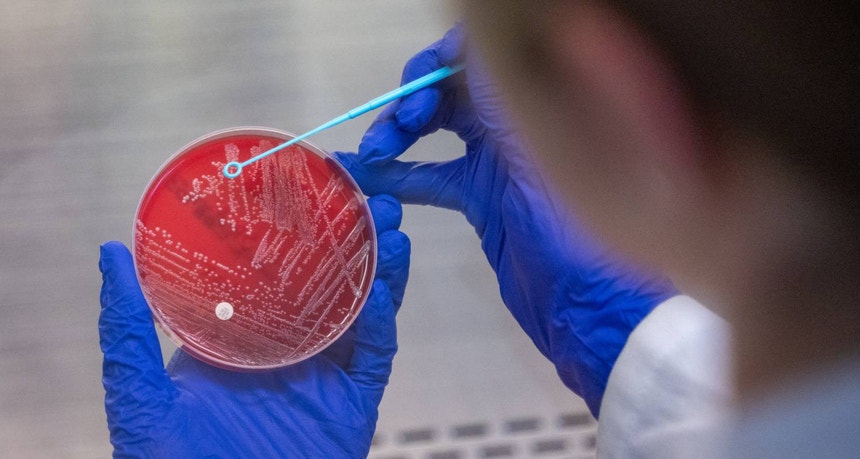

Mundo
A resistência a antibióticos pode matar milhões de pessoas até 2050 e custar biliões de euros por ano
A resistência a antibióticos pode matar milhões de pessoas em todo o mundo no próximo quarto de século e custar cerca de 1,70 biliões de euros, de acordo um estudo divulgado esta segunda-feira que revela o impacto desastroso na economia global e na saúde. Os países da UE, EUA e Reino Unido estariam entre os mais afetados.
Se uma ação concertada dos países envolvidos, o aumento das taxas de resistência antimicrobiana (RAM) podem levar a perdas anuais globais do Produto Interno Bruto (PIB) de 1,7 biliões até 2050.
A conclusão é de um estudo, realizado pelo Center for Global Development, financiado pelo governo do Reino Unido que anunciou na semana passada cortes na ajuda ao desenvolvimento, nomeadamente ao financiamento de um fundo que combate a resistência aos antibióticos em países de baixo e médio rendimento.
A mesma tendência seguida por vários países europeus e liderada pela administração norte-americana de Donald Trump que anunciou cortes de nove mil milhões de euros no seu orçamento de ajuda externa, o equivalente a oito mil milhões de euros.
Anthony McDonnell, principal autor do estudo e investigador de políticas do Center for Global Development, explica ao diário britânico The Guardian: "Quando conduzimos a nossa pesquisa sobre os impactos económicos da resistência antimicrobiana, previa-se que as taxas de resistência continuariam a seguir as tendências históricas".
No entanto, os cortes drásticos na Ajuda Oficial ao Desenvolvimento pelos EUA e a redução da despesa em ajuda anunciada pelo Reino Unido, França ou Alemanha podem ser contraprudecentes e fazer aumentar as taxas de resistência antimicrobiana em todo o mundo.
"Mesmo os países que têm conseguido manter as taxas de RAM sob controlo não podem dar-se ao luxo de ser complacentes. A menos que os programas de resistência antimicrobiana sejam protegidos dos cortes na ajuda, as taxas de resistência em todo o mundo provavelmente aumentarão a um ritmo semelhante ao dos países mais afetados".
Anthony McDonnell alerta que prosseguir a tendência de cortes na ajuda ao desenvolvimento "resultaria na morte de milhões de pessoas em todo o mundo, incluindo nos países do G7". Pelo contrário, defende que investir no tratamento de infeções bacterianas ajudará a salvar vidas e proporcionará milhares de milhões em retorno económico a longo prazo.
"Infeção simples pode tornar-se mortal"
De acordo com o Instituto de Métricas e Avaliação da Saúde (IHME), as mortes por resistência antimicrobiana deverão aumentar 60 por cento até 2050 em todo o mundo, assim como o número de pessoas que adoecem gravemente devido às superbactérias que resistem aos medicamentos.
Mohsen Naghavi, professor no Instituto de Métricas e Avaliação da Saúde, alerta que que os antibióticos são ineficazes contra os vírus e que sem uma ação concertada e o desenvolvimento de novos medicamentos "uma infeção simples pode tornar-se mortal", escreve o The Guardian.
"Hoje, a ameaça da RAM está a aumentar e, sem uma ação imediata de todas as partes interessadas, os medicamentos aos quais temos acesso agora podem deixar de funcionar, potencialmente fazendo com que uma infecção simples se torne mortal".
Segundo as previsões mais pessimistas do estudo, as perdas no PIB da China podem atingir até 2050 cerca de 722 mil milhões de dólares por ano, 295 mil milhões nos EUA, 187 mil milhões na UE e 58,6 mil milhões no Reino Unido. Ao passo que um maior investimento poderia fazer a economia mundial crescer, nos EUA 156,2 mil milhões por ano e a do Reino Unido 12 mil milhões até 2050.







